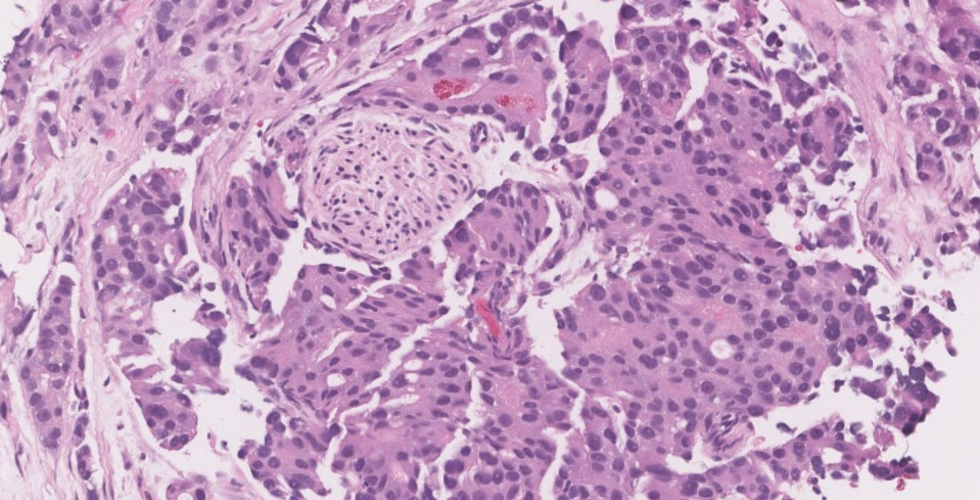
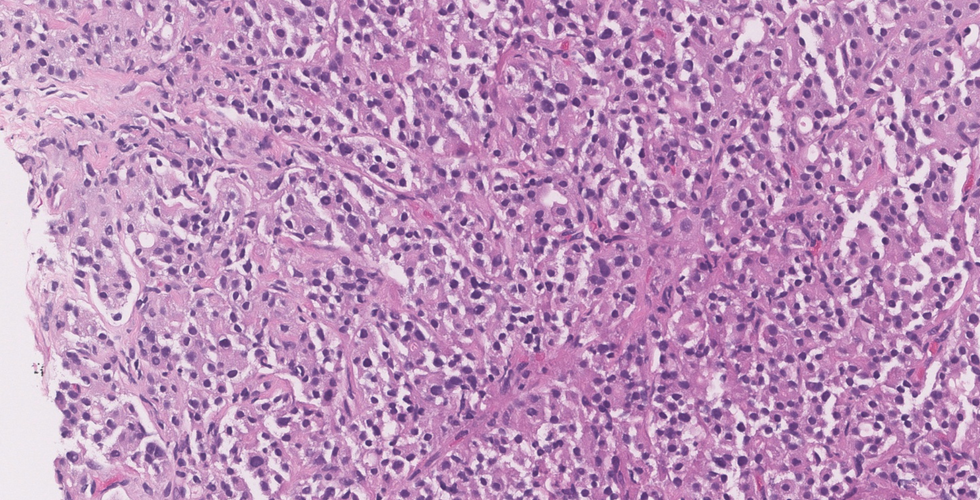

Case 3 - 68 year old male with elevated PSA
- Sep 25, 2020
- 10 min read
Scroll down for final diagnosis and discussionFinal diagnosis:
Invasive prostatic adenocarcinoma, acinar variant, Gleasons score 7/10 (3+4); Grade Group 2
Microscopic description:
This case shows crowded discrete small glandular proliferation, with few poorly formed/fused glands and occasional cribriform pattern, infiltrating in between benign glands
Glands have sharp lumina occasionally containing crystalloids; the cytoplasm is amphophilic, distinct from adjacent benign glands which has a pale character.
Nuclei are enlarged and hyperchromatic with prominently enlarged nucleoli
Malignant glands are lacking basal cells by IHC
Focus of perineural invasion is noted.
High yield facts on prostate cancer:
Clinical features
Most common cancer in men >50 years
Asymptomatic tumors detected by routine PSA level screening,
Urinary symptoms seen in late stages
Back pain is the initial presentation in patients who present with metastases to bone
Screening methods: Digital rectal examination, PSA levels, and transrectal ultrasound with biopsy

Causes of elevated PSA other than cancer:
BPH, infection, prostatic infarction, urethral instrumentation Gross pathology
Specimen types:
TURP chipping
Needle core biopsies
Simple prostatectomy
Radical prostatectomy Specimen Handling:
TURP chippings:
If specimen weight is </= 12 g then submit entire tissue;
If specimen weighs >12 g, submit the first 12 g (6-8 cassettes; each cassette holds about 2 g) and one cassette for every additional 5 g
If incidental prostate cancer comprises < 5% of tissues examined, entire remaining tissue should be submitted

Needle core biopsy:
Try avoiding accessioning prostate biopsy specimens in sequence to avoid specimen mix-up
Count and document number of cores per container
Submit 1-2 tissue cores per cassette
Prospectively cut intervening unstained slides to ensure presence of atypical focus for immunohistochemical stains
- Levels 1, 3, and 5 for H&E staining
- Save unstained levels 2, 4, and 6 for potential IHC or H&E stains

Radical Prostatectomy:
1. Fix in neutral buffered formalin for 18-24 hours
2. Weigh and measure specimen in 3 dimensions
3. Orientation: Determine where the right and left, apex (inferior) and base (superior), as well as the anterior and posterior surfaces are. Seminal vesicles are a useful landmark as they are located near posterior surface; the posterior surface is more smooth and flat as compared to anterior surface which is rough and convex. Placing a probe through the urethra also helps localize the apex and base.
4. Ink the outer surface using two colors to identify right and left side

5. Amputate the seminal vesicle and vas deferens
Sections of prostatic tissue at base, including adjacent attached seminal vesicle, are needed to demonstrate direct tumor extension
Not necessary to submit entire seminal vesicle

6. Sample margins: Apex and base amputated and subsequently sectioned perpendicular to inked surface
7. Serially section coronally the middle portion at 3-5 mm intervals; each slice is then divided into 4 quadrant (left anterior, left posterior, right anterior, right posterior)
Sections submitted from remainder of gland ranges from systematic partial sampling to entire prostate submission
Systematic sampling allows for accurate assessment of tumor measurements, focality, and location of margin and EPE positivity



8. Cassettes should be in order according to template

Grossing images references:
The grossing images on this site have been referenced from the credited authors and links below:
Radical prostatectomy grossing, Youtube video channel by Andrey Glotov and Natalia Ratnikova:
Prostatectomy grossing, cutting manual by University of Michigan; by Dr. Kunju,M. Weighman, M. Gabbeart
The Royal College of Pathologists of Australasia Grossing Manual:
Prostatectomy grossing and standard cassette template by The University of Michigan
Microscopic Pathology
Histologic subtypes:
· 90-95 % of prostate cancers are acinar adenocarcinoma including its variants: atrophic, pseudo-hyperplastic, microcystic, foamy cell, mucinous (colloid), signet ring cell, pleomorphic giant cell, and sarcomatoid types
· 5–10% of prostate cancers are of non-acinar origin: ductal adenocarcinoma, urothelial carcinoma, squamous cell/adenosquamous, and basal cell carcinoma
Acinar adenocarcinoma: Microscopic features
● Diagnosis requires a number of features such as architectural, nuclear, cytoplasmic, and luminal changes.
● Proliferation and crowding of uniform, small acini having irregular contours, which infiltrate between adjacent benign prostate glands.
● Acini are lined by a single layer of epithelial cells; basal cell layer is absent (basal cell IHC markers such as p63 and HMWK are negative)
● Nuclei are large, hyperchromatic with one or more prominent macronucleoli
● The cells are cuboidal or columnar with amphophilic cytoplasm (compared to more pale/foamy cytoplasm of adjacent benign prostatic glands)
● Various patterns are seen in high grade tumors including poorly formed/fused glands, cribriform/glomeruloid glands, cords, sheets or single cells
● Mitotic figures uncommon in low-grade tumors

Did you know?
Mucinous fibroplasia, collagenous micronodules, circumferential perineural invasion and extra-prostatic fat invasion are pathognomonic features of prostatic carcinomaAcinar Adenocarcinoma Variants:
Reference: Diagnostic pathology genitourinary by TICKOO

Pick your battles wisely!
Knowledge of variants is important for several reasons:
- Prognostic/survival difference
- Can resemble/imitate benign lesions (e.g pseudohyperplastic/foamy gland variants are bland)
- Can imitate none prostatic carcinomas (bladder/GI tract)
- Modification of grading method for some variantsPseudohyperplastic Adenocarcinoma
Resembles benign hyperplastic glands in terms of architecture but has atypical nuclear features
ISUP recommends grading them as Gleason 3+3= 6
Usually there is loss of basal cell markers and over-expression of AMACR
Pic source: Librepathology
Microcystic Adenocarcinoma
● Seen in upto 11% of radical prostatectomy specimens
● Dilated glands: More than tenfold in comparison to acinar form
● Distinguish from benign cystic glands with IHC for basal markers
Colloid (Mucinous) Adenocarcinoma
● Minimum 25% of tumor should consist of extracellular mucin lakes
● Typically associated with acinar-type adenocarcinoma
● ISUP recommends grading them according to architecture; most are Gleason grade 4 (cribriform pattern is most common)
● Distinguish from secondary colorectal or bladder cancer. A bladder/urethral origin tumour will show CK7/CK20 positivity, and colorectum CK20/CDX-2/β catenin positivity.

Signet Ring Cell Adenocarcinoma
● Rare
● ≥25% of the tumour area should signet ring cells
● Distinguish from secondary gastric or colorectal cancer (not mixed with conventional acinar adenocarcinoma and are negative for PSA IHC)

Atrophic Adenocarcinoma
● Mimics benign atrophy or post atrophic hyperplasia.
● Co-exists with acinar adenocarcinoma usually

Source: Diagnostic pathology genitourinary TICKOO
Pleomorphic Giant Cell Adenocarcinoma
● Rare with poor prognosis
● Can also be seen post hormone therapy or radiation treatment
● Usually seen with Gleason 9 or 10 tumour
Sarcomatoid Carcinoma
● Rare, with aggressive clinical course.
● Hard gland with enlargement can show sarcomatoid transformation of prior adenocarcinoma or be related to radiotherapy/hormonal therapy
Source: Diagnostic pathology genitourinary TICKOO
Non-Acinar Adenocarcinoma: Microscopic features
Ductal type Adenocarcinoma
● Usually involves the larger periurethral prostatic ducts (centrally located)
● Research has shown that these are more aggressive than conventional acinar type
● Can occur in pure forms or mixed with conventional acinar adenocarcinoma
● Papillary, cribriform and/or solid architecture composed of pseudostratified tall columnar cells; comedo necrosis may be seen
● Atypical large nuclei with coarse chromatin and large nucleoli seen
● Basal cells are absent (negative p63/HMWK)
● It is suggested to grade them as Gleason grade 4; if necrosis is present then they are grade 5

Other rare prostatic tumor types: Detailed discussion of these tumors is beyond the scope of this page but overall their pathologic features are similar to their counterparts occurring more commonly in other organs
Small-cell neuroendocrine carcinoma,
Adenosquamous/Squamous Cell Carcinoma,
Urothelial (Transitional Cell) Carcinoma,
Basal Cell Carcinoma, Clear Cell Carcinoma,
Mesenchymal tumors,
Hematolymphoid tumors
Secondary tumors involving prostate by direct extension or metastasis
Staging and grading
Gleason grading system: One of the most powerful prognostic predictors of prostate cancer
Characteristics:
● Low to intermediate power view of architectural patterns of the tumor
● Patterns are grouped into five grades based upon ability to form glands (i.e., differentiation): Patterns range from 1 through 5, with 1 being the most well differentiated, whereas 5 is the least differentiated
● Gleason score is the sum of the primary and secondary Gleason patterns
ISUP recommendations for
Radical prostatectomy: Primary pattern is the most prevalent pattern and secondary is the second most common pattern; separately mention the tertiary pattern if present (however, tertiary pattern is upgraded as secondary pattern if >5%)
Needle core biopsies:
If only one Gleason pattern is present, it is multiplied by 2 to get the Gleason score
Primary pattern is the most prevalent pattern and any amount of the worst pattern is graded as secondary
For example: A core needle biopsy which shows 97% Gleason pattern 3 and 3% Gleason pattern 4, is calculated as Gleason score 3+4=7For cancers with more than two patterns, you include tertiary pattern in Gleason score if it is higher than secondary pattern
For example: a core needle biopsy which shows 60% Gleason pattern 3, 30% pattern 4 and 10% pattern 5 is calculated as Gleason score 3+5= 8In high-grade cancers, ignore lower grade Gleason pattern if < 5%
For example: a core needle biopsy which shows 96% Gleason pattern 4 and 4% pattern 3 is calculated as Gleason score 4+4=8● Grading helps in assessing malignant potential and therapeutic decisions
● With increase in score, the tumor is more aggressive and poorly differentiated
International Society of Urological Pathology Modified Gleason Grading of Prostatic Carcinoma:
● Gleason pattern 1: Circumscribed nodule of uniform, closely packed, medium-sized (larger than pattern 3) acini that does not invade adjacent prostatic tissue
● Gleason pattern 2: Like pattern 1 but less well circumscribed nodule (little infiltration at periphery) and less uniform and more loosely arranged acini
● Gleason pattern 3: Usually smaller but well formed glands which invade between benign ducts and acini
● Gleason pattern 4: Fused, irregular, infiltrative glands with poorly formed glandular lumina -or- smoothly circumscribed, large cribriform glands -or- poorly circumscribed (irregular) cribriform glands -or- hypernephroid (renal cell carcinoma-like)
● Gleason pattern 5: Sheets, cords or individual cells essentially lacking gland lumina -or- any pattern with comedo-type necrosis

Tip: Gleason patterns 1 and 2 are not diagnosed on core needle biopsy; they are condensed under pattern 3.Grade Group: reference article Grading of prostatic adenocarcinoma: current state and prognostic implications
The new grading system includes five distinct grade groups and is based on the modified Gleason score groups. It is more simpler and more accurately predicts prostate cancer biology, thus improved clinical stratification of prostate cancer patients.
Grade Group and Gleason Score
Grade group 1 (Gleason Score 3+3=6)
Grade group 2 (Gleason Score 3+4=7)
Grade group 3 (Gleason Score 4+3=7)
Grade group 4 (Gleason Score 4+4=8)
Grade group 4 (Gleason Score 3+5=8)
Grade group 4 (Gleason Score 5+3=8)
Grade group 5 (Gleason Score 4+5=9)
Grade group 5 (Gleason Score 5+4=9)
Grade group 5 (Gleason Score 5+5=10)Note: The image below is adopted from John Hopkin's Dr. Epstein, which is super helpful to have beside your microscope when grading prostate cancers.

Pathologic Stage Classification (pTNM, AJCC 8th Edition)
Primary Tumor (pT)
● pT2: Organ confined
● pT3: Extraprostatic extension
● pT3a: Extraprostatic extension (unilateral or bilateral) or microscopic invasion of bladder neck
● pT3b: Tumor invades seminal vesicle(s)
● pT4: Tumor is fixed or invades adjacent structures other than seminal vesicles such as external sphincter, rectum, bladder, levator muscles, and/or pelvic wall
Regional Lymph Nodes (pN)
● pNX: Regional lymph nodes cannot be assessed
● pN0: No positive regional nodes
● pN1: Metastases in regional node(s)
Distant Metastasis (pM) (required only if confirmed pathologically in this case)
● pM1: Distant metastasis
● pM1a: Non Regional lymph nodes(s)
● pM1b: Bone(s)
● pM1c: Other site(s) with or without bone disease

Special Stains and Immunohistochemistry
Prostate specific markers
● PSA and prostatic acid phosphatase (PAP)
● Useful in confirmation of prostatic origin of tumor in the setting of metastatis/ detection of metastatic prostatic adenocarcinoma
● Positive in variants of prostate cancer: mucinous, signet ring cell, ductal- type and in epithelial component of carcinosarcoma
AMACR
● Sensitive and specific marker for acinar adenocarcinoma; positive in 82% to 100% of cases
● Less sensitive in low-grade and hormone-treated conventional prostate cancer and prostate cancer variants, such as foamy gland, pseudohyperplastic, atrophic-type, and ductal-type prostate cancers
● AMACR is less useful in evaluating metastases because many tumors in other organs (kidney) are immunopositive
HMWCK and p63
● Stains of basal cell cytoplasm (HMWCK) and nuclei (p63); negative in adenocarcinoma because basal cells are absent
Molecular pathology
● 8q24 genetic variant associated with prostate cancer risk
● TMPRSS2-ERG fusion, an early molecular event in the development of prostate cancer
● Flow cytometry: diploid tumors more favorable outcome than tumours with aneuploidy
Prognosis
The following is list of adverse prognostic factors in prostate cancer:
● Risk of tumor recurrence decided based on stage, Gleason score and serum PSA at diagnosis:
Low risk: pT1 – pT2a, Gleason ≤6, PSA < 10 ng/mL
Intermediate risk: pT2b – pT2c, Gleason 7, PSA 10–20 ng/mL, or,
High risk: pT3 – pT4, Gleason 8–10, PSA > 20 ng/mL
● Perineural and Lymphovascular Invasion:
· Seen in 75–90% of radical prostatectomy specimens.
· Indicator of potential extra- prostatic extension, and is associated with higher Gleason score and volume.
● Tumor quantity/tumor volume:
Radical prostatectomy: An approximation of percentage of prostate involved by tumor (visual inspection/eyeballing)
Needle biopsy: Number of positive cores and percentage &/or linear extent of tumor in mm
● Extraprostatic extension: is defined by any of the features below
Presence of tumor beyond the confines of the prostate gland
Tumor extension into fat;
Tumor involving loose connective tissue in the plane of fat or beyond;
Tumor involves perineural spaces in the neurovascular bundles, even in the absence of periprostatic fat involvement
Descriptors used when reporting EPE: focal and non-focal
Note: Prostate does not have a true capsule
● Margin status:
Positive margin: When tumor reaches the inked surface;
Descriptors of positive margin:
Extent of margin involvement by tumor in mm;
Focality (focal or multifocal margin involvement);
Location of margin positivity
Capsular incision (iatrogenic/pT2+/pTX) or non-iatrogenic (tumor is transected at EPE)
Differential diagnoses of prostatic adenocarcinoma
Due to the wide range of patterns for prostatic adenocarcinoma, the differential diagnosis is extensive, ranging from benign prostatic lesions to premalignant lesions and even secondary cancers involving the prostate.

Tips for avoiding false positive prostate carcinoma:
Various benign prostatic lesions and processes can mimic prostate adenocarcinoma especially in needle core biopsies; thus, knowledge of these entities, a pattern based approach, and appropriate use of ancillary stains is crucial to avoid these pitfalls.
Benign mimickers of prostate carcinoma:
Pathophysiological processes: Atrophy, hyperplasia, adenosis,
Normal structures: Seminal vesicle tissue, Cowper's gland, verumontanum glands, mesonephric glands, paraganglion,
Inflammatory lesions: Granulomatous prostatitis, xanthogranulomatous inflammation, malakoplakia, acute and chronic prostatitis
Note: I highly recommend this article by John R Srigley: Benign mimickers of prostatic adenocarcinoma
Premalignant lesions:
High grade prostatic intraepithelial neoplasia (PIN)
● Usually large acini lined by hyperplastic, pseudostratified epithelial cells with elongated, large nuclei and prominent nucleoli
● Four Architectural patterns: Flat, cribriform, micropapillary, tufted
● HMWCK or p63 highlights preserved basal cells (occasionally attenuated or discontinous staining of basal cells may occur)
● AMACR may show granular, apical cytoplasmic positivity in contrast to more diffuse staining seen in carcinoma
Atypical small acinar proliferation (ASAP):
It is a descriptive rather then a diagnostic disease entity, in which there is a focus of small atypical glandular proliferation, that quantitatively &/or qualitatively not enough for unequivocal cancer diagnosis or exclusion
Differentials of ASAP: Focal prostate carcinoma and benign glandular lesions
ASAP can be positive for AMACR and lack basal cells
ASAP warrants re-biopsy, as the literature has shown a greater chance of finding cancer on re-biopsy samples.
Quality control: ASAP is reported in about 5-10% of needle core biopsies, according to the literature.
How to sign out the case
Procedure
● Radical prostatectomy
Histologic Type
● Acinar adenocarcinoma
Histologic Grade
● Grade group 1 (Gleason Score 3+3=6)
Extraprostatic Tumor Extension
● Present, focal
Location of Extraprostatic Extension
● Right apical
● Right bladder neck
Urinary Bladder Neck Invasion
● Not identified
● Present
Seminal Vesicle Invasion
● Not identified
● Present: Right
Lymphovascular Invasion
● Present/ absent
Perineural Invasion
● Present/ absent
Regional Lymph Nodes
● Present/ absent
Pathologic Stage Classification (pTNM, AJCC 8th Edition)
References
Surgical Pathology Dissection: An Illustrated Guide 2nd edition
Rosai and Ackerman’s Surgical Pathology, 11th edition
Mills, Stacey E. Sternberg’s Diagnostic Surgical Pathology
Differential diagnosis in surgical pathology, Third edition 2015
WHO Classification of Tumours of the Urinary System and Male Genital Organs, 4th Edition, Volume 8 by Moch H, Humphrey PA, Ulbright TM, Reuter VE, 2016
Histopathology reporting. Derek C. Allen. Guidelines for surgical cancer. Third edition
https://www.cap.org/protocols-and-guidelines/cancer-reporting-tools/cancer-protocol-templates
rcpa.edu.au

Comments